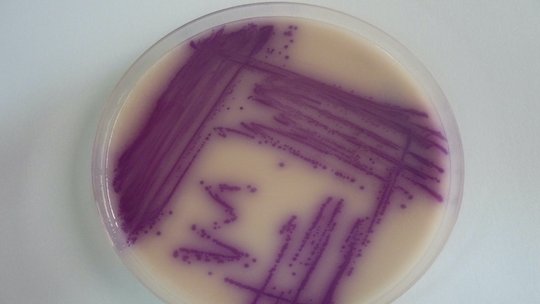
Zu sehen ist eine Petrischalfe in denen die Erreger sich Lila absetzen

Antibiotic resistant enteric pathogens in human and animal reservoirs
In resource-limited countries, broad-spectrum antibiotics are often prescribed empirically without microbiological diagnosis. This overuse of antibiotics in human medicine, significantly contributes to the emergence and the increase of multidrug-resistance. In addition, the use of antibiotics in animal husbandry as growth promoters and for prophylaxis and treatment of infection aggravates this problem. Often, in countries where resources are limited, animal farming is a common occupancy and people often live in close proximity to animals. Animals and meat products have been suggested as an important source for drug resistant enteric pathogens including Campylobacter spp., Arcobacter spp., Salmonella enterica, ESBL-producing Escherichia coli and Klebsiella pneumoniae in SSA countries. Transmission of these bacteria might occur by direct contact or consumption of contaminated meat products, leading to the colonization of the intestinal tract and eventually to infections. So far, the degree to which animals play a role as a reservoir for the transmission of multi drug resistant bacteria has not been studied on genotype level in rural areas of SSA. Within this project, Campylobacter spp., Arcobacter spp., Salmonella enterica, ESBL-producing E. coli and K. pneumoniae genomes collected from human and animals will be compared to examine transmission between human and animal in rural areas of Tanzania and Ghana.
Partners:
Kumasi Centre for Collaborative Research in Tropical Medicine (KCCR), Kumasi, Ghana
Agogo Presbyterian Hospital, Agogo, Ghana
National Institute for Medical Research (NIMR) in Tanga, Tanzania
Korogwe District hospital, Korogwe, Tanzania
Funding:
German Research Foundation (DFG)

Bacterial subtypes and their association with diarrhoea
Globally, one in ten child deaths during the first five years of life result from diarrhoeal disease. Due to limitations in diagnostic facilities in resource-constrained clinical settings, the aetiological agent of diarrhoeal disease is rarely laboratory confirmed. In the past years, clinical studies on diarrheal diseases in developing countries have shed more light on the predominating causes of infection. Campylobacter spp., Shigella spp., and diarrhoeagenic Escherichia coli and Salmonella enterica have been among the most common pathogens isolated from patients with diarrhoea. So far, studies on Arcobacter spp. are limited. Arcobacter spp. is an emerging pathogen with its role in diarrhoeal disease not well understood. In the past years, moderate associations with diarrhoea have been demonstrated for Shigella spp., Campylobacter spp. and diarrhoeagenic Escherichia coli but the associations on bacterial sub-type level have not been studied thoroughly. Data on sub-type specific burden of diarrhoea and antibiotic resistance is needed in order to identify populations at risk, to develop preventive measures and to adjust antibiotic usage when treatment is indicated.
Within this study we investigate and compare bacterial subtypes of children below 5 years of age and the association with diarrhoea in a rural hospital in Tanzania.
Partners:
National Institute for Medical Research (NIMR) in Tanga, Tanzania
Korogwe District hospital, Korogwe, Tanzania
Funding:
German Center for Infection Research (DZIF)